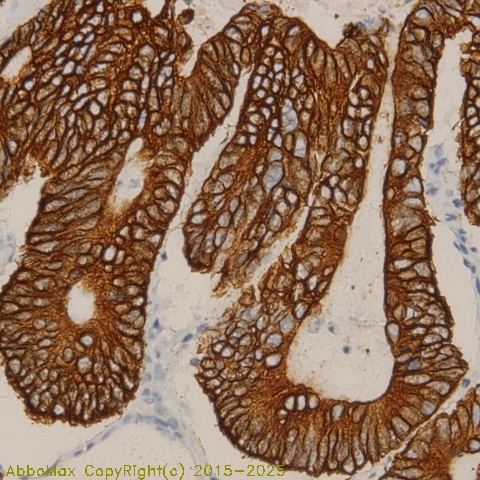

PPP2R5C
B56G, Protein phosphatase 2 regulatory subunit B (B56) gamma isoform, PPP2R5C
 Download Product PDF
Download Product PDF
 MSDS Download Product PDF
MSDS Download Product PDF
Antigen Preparation
A recombinant protein PPP2R5C
Background
"Serine/threonine-protein phosphatase 2A 56 kDa regulatory subunit gamma isoform is an enzyme that belongs to the phosphatase 2A regulatory subunit B family. Protein phosphatase 2A is one of the four major Ser/Thr phosphatases, and it is implicated in the negative control of cell growth and division. It consists of a common heteromeric core enzyme, which is composed of a catalytic subunit and a constant regulatory subunit, that associates with a variety of regulatory subunits. The B regulatory subunit might modulate substrate selectivity and catalytic activity. This gene encodes a gamma isoform of the regulatory subunit B56 subfamily. PPP2R5C represents an important factor in the functional wiring of energy metabolism and the maintenance of a metabolically healthy state. Hepatic levels of PPP2R5C are elevated in human diabetic patients, and correlate with obesity and insulin resistance in these subjects.
It was reported that knockdown of PPP2R5C by siRNA leads to proliferation inhibition and apoptosis induction in K562 cells. The mechanism for proliferation inhibition and increased apoptosis of K562 cells following PPP2R5C suppression may be related to the alteration of expression profiles of BRAF, AKT2, AKT3, NFKB2 and STAT3 genes.
"
PURIFICATION
The mouse IgG is purified by Protein A-Affinity Chromatography according to Isotyping
|
SPECIFICITY
This antibody recognizes human PPP2R5C protein. The other species are not tested.
|
FORMULATION
This affinity purified antibody is supplied in sterile Phosphatebuffered saline (pH7.2) containing antibody stabilizer
|
STORAGE
The antibodies are stable for 24 months from date of receipt when stored at –20oC to –70oC. The antibodies can be stored at 2oC-8oC for three month without detectable loss of activity. Avoid repeated freezing-thawing cycles.
|
Applications/Suggested Working Dilutions
|
|
|
Immunoprecipitation
2-5 µg/ml
|
|
Flow cytometry
Not tested
|